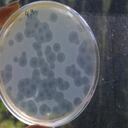
Los investigadores analizaron 124 adultos y descubrieron que la mayoría de los sistemas digestivos tienen mucho en común: al menos 57 especies de bacterias estaban en casi todos los humanos. En total, los científicos catalogaron cerca de 1.000 especies diferentes y suponen que hay unas 150 más que no encontraron.

Un primer caso de la nueva cepa de la covid-19, que surgió en el Reino Unido, fue detectado este viernes en la localidad de Tours, en el centro de Francia, anunció el Ministerio de Salud nacional.
El primer paciente positivo confirmado de la nueva variante del virus es un francés que reside en el Reino Unido y que es asintomático, informó el ministerio en un comunicado, en el que precisó que el contagiado fue aislado en cuarentena.
Tras haber llegado “de Londres el 19 de diciembre (...), recibió atención médica en un hospital y el día 21 dio positivo”, indicó el ministerio, que aseguró que se trata del “primer contagiado por la variante VOC 202012/01” en territorio francés.
Según lo previsto en el protocolo puesto en marcha tras el descubrimiento de esta cepa –posiblemente más contagiosa– en el sureste del Reino Unido, se solicitó una “secuenciación” del virus que portaba este enfermo al Centro de Referencia Nacional de Virus de Infecciones Respiratorias. Este último confirmó el viernes la infección con variante VOC 202012/01.
“Los responsables sanitarios iniciaron un rastreo de los profesionales médicos que se ocuparon del paciente y de las personas con las que estuvo en contacto, para que estas se aíslen de manera estricta”, indicó el comunicado.
Además de este caso, “hasta ahora varias muestras positivas que podrían deberse a la variante VOC 202012/01 están siendo secuenciadas por los laboratorios” del Centro de Referencia Nacional, agregó el ministerio.

Las primeras dosis de la vacuna contra el coronavirus desarrollada por el laboratorio estadounidense Pfizer y el alemán BioNTech llegaron el sábado por la mañana a la farmacia central del organismo de Hospitales de París, en las afueras de la capital francesa, constató una periodista de la AFP.
Como en otros países de la Unión Europea, la vacunación comenzará el domingo en Francia, donde más de 62.000 personas murieron por la covid-19.
Las primeras inyecciones se efectuarán en dos residencias de ancianos, en Sevran, cerca de París, y en Dijon, en el este del país.
Unas 19.500 dosis de la vacuna en 3.900 frascos, según las autoridades sanitarias, fueron transportadas a bordo de un camión frigorífico que hizo el trayecto desde la fábrica de Pfizer en Puurs, en Bélgica.
Europa superó este viernes el trágico umbral de 25 millones de casos de coronavirus, en una pandemia que ha ensombrecido estas Navidades en todo el mundo, mientras varios países latinoamericanos lanzaron sus campañas de vacunación.
Europa, que a mediados de diciembre fue la primera región en superar el medio millón de muertos, es la más afectada en el mundo en número de contagios, según un recuento de la AFP basado en fuentes oficiales.
En total, a nivel global la covid-19 ha matado a más de 1,7 millones de personas y contagiado a más de 79 millones.
En su tradicional mensaje de Navidad, el papa Francisco insistió en “la necesidad de fraternidad” en este momento de la historia, “marcado por la crisis ecológica y por los graves desequilibrios económicos y sociales, agravados por la pandemia del coronavirus”.
